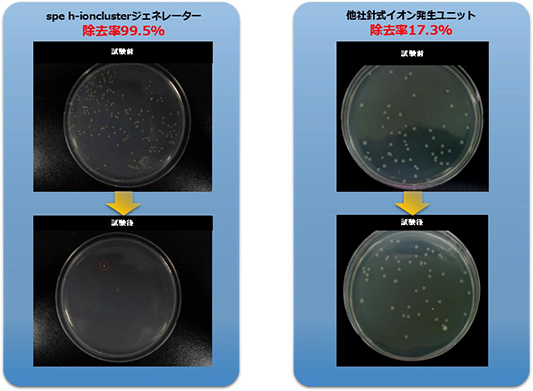

- トップページ≫
- Venti イオンクラスター除菌脱臭装置
強力なイオンクラスターの力で除菌・脱臭・VOC対策!
1934年、イオンクラスターと呼ばれる物質が存在することがロシアの物理学者たちにより発見されました。
イオンクラスターは酸素分子のイオンの集合体で空気中にも存在します。
雷などの高エネルギー発生源により、空気のイオン化が誘発され生成されたイオンクラスターが存在します。
このイオン化された空気が地球上の大気の浄化作用を行っていたのです。
自然の原理から生まれたイオンクラスターにより快適な環境づくりを目指しています。
開発・製造 株式会社spe
WMシリーズの特徴
弊社のオリジナル商品のため、他では取り扱いはございません。
また、従来のものよりサイズをコンパクトにし、なおかつ壁掛けのため邪魔になりません。
埋め込み式ではないので、ダクト工事も不要です。
色も白と黒をご用意しております。

| 消費電力(W) | 7W |
|---|---|
| 寸法 | 160mm(W)×160mm(H)×100mm(D) |
| 適用床面積 ※使用環境により変わります | 40㎡ |
| 重量(Kg) | 1kg |
| 使用電源 ※壁からの直結またはAC100Vコンセント差込対応です | DC12V |
| 騒音 | 45dB |

学看護学部感染制御学研究所(本学:東京都大田区 小林寅喆教授)はh-ioncluster「Venti」に搭載されているイオン発生素子AIO-2によるヒトコロナウィルス及び院内感染対策上問題となる各種抗菌薬耐性菌への殺菌試験を実施し、その効果が認められ、権威ある英国科学誌「Journal of Hospital Infection」に論文が掲載されました。
調査結果トピックス
- ・ ヒトコロナウィルスを用いた実証試験において2時間後に94%のヒトコロナウィルスの不活化(感染価の減少)が実証されました。
- ・ 主な院内感染原因菌であるMRSA(メチシリン耐性黄色ブドウ球菌)では4時間後に99.4%の殺菌効果が実証されました。そのほか、MDRP(多剤耐性緑膿菌)や芽胞をもつディフィシル菌などにも効果が実証されました。
- ・ すべての実証試験において試験環境を人体に害を及ぼす可能性の低いオゾン濃度0.066ppm以下に抑え、イオンクラスターの各種病原体への効果を実証できました。
もし特定の感染症にかかったら…
+保険安心サービス
を始めました。

■据置き壁掛け
■省エネ 年間電気料金約1,500円
(「強」モードにて1日24時間使用時の例。電気料金26円/kWhで計算)
■簡単メンテナンス フィルター交換不要
| 型番:WT-002-A | 標準仕様 | ダブルパッケージ適用時 |
|---|---|---|
| イオンクラスター発生素子 | AIO-2 × 1本 | AIO-2 × 2本 |
| 運転モード | 弱/強/ターボ | 弱/強/ターボ |
| 消費電力 | 10W | 12W |
| 適用床面積 (使用環境により適用床面積は異なります) |
約40㎡(約25畳) | 約60㎡(約40畳) |
| 重 量 | 3.5kg | 3.9kg |
| 使用電源 | DC12V,3.5A専用ACアダプター | DC12V,3.5A専用ACアダプター |
| 寸 法 | 幅210mm×奥121mm×高297mm | 幅210mm×奥121mm×高297mm |

■キャスター付き移動型
■より強力なパワー AIO-DIX搭載
■大型タイプ
■広い空間の除菌・脱臭
| イオンクラスター発生素子 | AIO-DIX × 1本 |
|---|---|
| 運転モード | 弱/中/強/ターボ |
| 消費電力 | 80W |
| 適用床面積 (使用環境により適用床面積は異なります) |
約100~400㎡ |
| 重 量 | 35kg |
| 使用電源 | DC24V,5A専用ACアダプター |
| 寸 法 | 幅640mm×奥340mm×高645mm |

■小型の空調ダクトに設置可能
■連続運転モードであっても消費電力がわずか2Wと省エネ(DIST-101-Aの場合)
■リモコンの接続が可能(オプション)
| 製品名 | DIST-101-A | DIST-102-A | DIST-103-A |
|---|---|---|---|
| イオンクラスター発生素子 | 1本 | 2本 | 3本 |
| 運転モード | 弱/強/連続 | 弱/強/連続 | 弱/強/連続 |
| 消費電力(W) | 1/1/2 | 1/2/3 | 2/3/4 |
共通項目
| 重 量 | 3.1kg |
|---|---|
| 使用電源 | DC12V直結 |
| 寸 法 | 幅320mm×奥244mm×高201.4mm |
| 適用床面積 (使用環境により適用床面積は異なります) |
約100~400㎡ |
| リモコン | ケーブルで接続可能(シグナル端子) |
| ダクト部 | ダクト接続部は取付及び取り外し可能 |
| 材 質 | スチール(粉体塗装) |
□発生素子は4本のものもございます。
※イオンクラスター発生素子は交換が必要です。装置の点検や交換作業のために点検口を必ず設置してください。


◇有害物質の除去による安全な室内環境の維持
高イオン化エネルギーを持つイオンクラスターによりVOC(揮発性有機化合物)や悪臭成分を分解します。
◇感染予防対策
細菌やウィルスの表面を破壊して除去します。
一般細菌、真菌類(カビ菌)、大腸菌、サルモネラ菌、黄色ブドウ球菌やウィルスに対して除去効果を発揮します。












